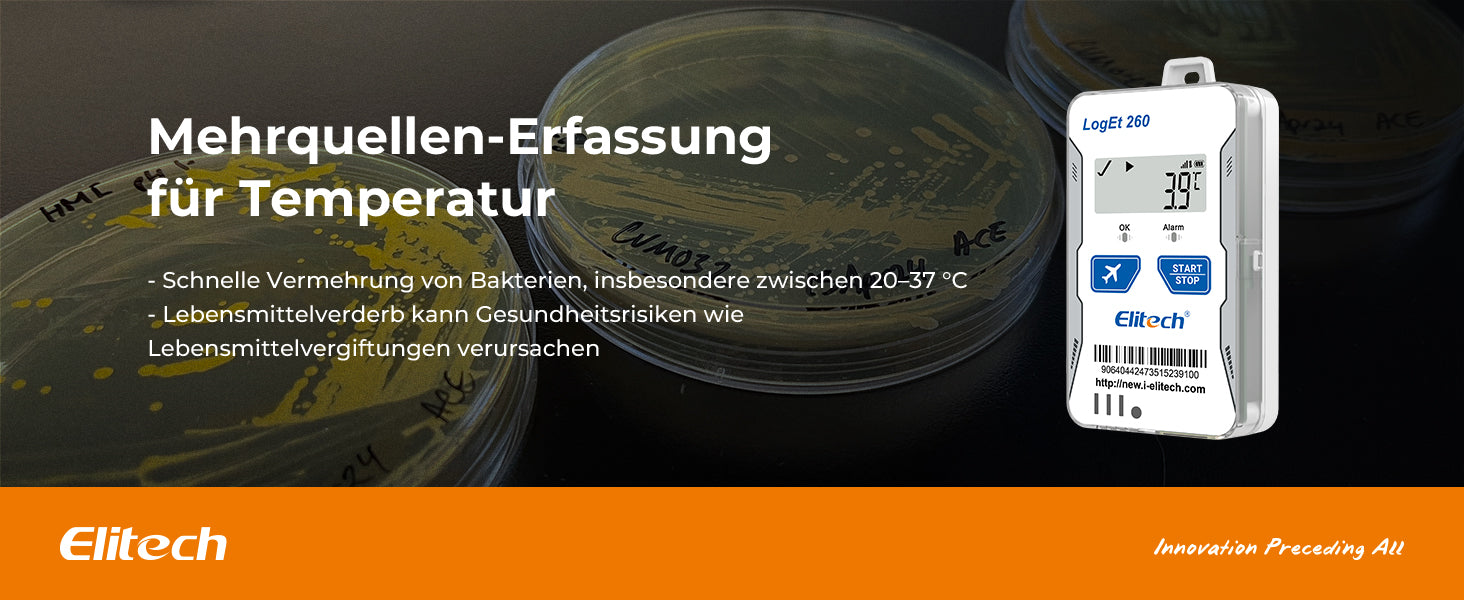

Elitech Loget 260-TH 4G wiederverwendbarer Echtzeit-Temperatur- und Feuchtigkeitsdatenlogger mit Licht-/Stoß-/Standorterfassung, integrierter SIM-Karte, 100.000 Messpunkten
Elitech Loget 260-TH 4G wiederverwendbarer Echtzeit-Temperatur- und Feuchtigkeitsdatenlogger mit Licht-/Stoß-/Standorterfassung, integrierter SIM-Karte, 100.000 Messpunkten
SKU:Loget 260-TH
Verfügbarkeit für Abholungen konnte nicht geladen werden
Elitech LogEt 260-TH ist ein 4G-fähiger intelligenter Datenlogger, der für die Echtzeitüberwachung von Temperatur, Luftfeuchtigkeit, Erschütterung und Standort entwickelt wurde. Mit Cloud-Speicherung, mehreren Alarmfunktionen und Flugmodus gewährleistet er eine sichere und zuverlässige Überwachung für Kühlkettenlogistik und empfindliche Sendungen.
Echtzeitüberwachung – Unterstützt 4G-Konnektivität zur Echtzeitverfolgung von Temperatur und Luftfeuchtigkeit sowie Standort-, Licht- und Stoßerkennung.
Integrierte SIM-Karte & Cloud-Speicherung – Wird mit vorinstallierter SIM-Karte geliefert und bietet Cloud-Datenspeicherung für den Fernzugriff und die Verwaltung.
Mehrere Alarmmethoden – Sendet Alarme per SMS, E-Mail, App-Benachrichtigungen und Web-Alarme, um rechtzeitige Reaktionen sicherzustellen.
Große Datenspeicherkapazität – Speichert bis zu 100.000 Datenpunkte und ermöglicht so eine langfristige und detaillierte Überwachung.
Flugmodus & Schatten-Daten – Verfügt über einen Flugmodus für den sicheren Lufttransport sowie eine Schatten-Datensicherung zur Vermeidung von Datenverlust.
Aktie